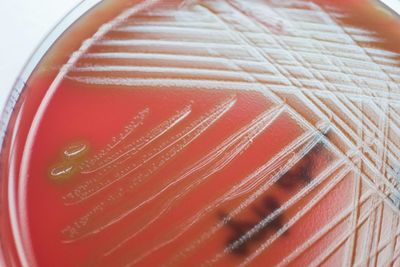
Evaluating the diagnostic utility of 16S ONT sequencing in patients with central nervous system infections and its usefulness in antimicrobial stewardship

Evaluating the diagnostic utility of 16S ONT sequencing in patients with central nervous system infections and its usefulness in antimicrobial stewardship
- Published on: May 26 2025
- Source: The Journal of Infectious Diseases
Culture-based diagnostics for central nervous system (CNS) infections can be slow and unreliable, particularly for patients already treated with antibiotics. This study showed that Oxford Nanopore 16S rRNA sequencing could rapidly and sensitively identify pathogens missed by culture, potentially supporting faster diagnosis and more targeted antibiotic use in the future — a critical step forward for antimicrobial stewardship in low-resource settings.
'By improving pathogen identification, guiding more accurate antibiotic therapy, and contributing to antimicrobial stewardship, 16S ONT sequencing has the potential to improve patient outcomes and combat AMR, particularly in resource-limited settings'
Van Dong et al. 2025
Sample type: cerebrospinal fluid
Kit: 16S Barcoding Kit